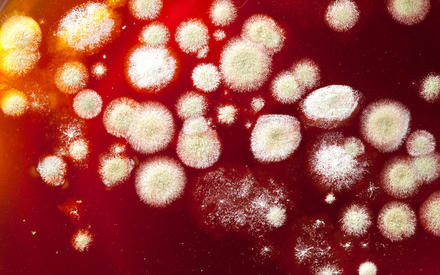

Чем опасна плесень?
nikkytok, new-union
Плесень – колония микроскопических грибков, способных появиться и развиваться практически на любой поверхности. Наверное, нет такого человека, который бы не сталкивался в своей жизни с плесенью, но не так много тех, кто знает, насколько опасно такое соседство.
Ученые выделяют около 200 тысяч видов плесневых грибков, примерно два десятка из них обитают в наших жилых помещениях, многие способны нанести ощутимый вред организму человека. Немало болезней являются следствием того, что человек живет рядом с плесенью или слишком часто с ней пересекается: грибковые поражения кожи (микозы), отравления, ринит, бронхит и болезни легких, болезни печени и желудочно-кишечного тракта, детский диатез, аллергия в разных формах, переходящая в астму, даже онкологические заболевания…
Грибки плесени в своем составе имеют активные ферменты, способные разлагать практические любые органические вещества. В первую очередь, разрушается поверхность, на которой образовалась плесень. При этом в окружающую среду выделяются опасные органические кислоты, токсические продукты жизнедеятельности грибков. А если плесневые грибки попадают в организм, то их ферменты разрушают оболочки клеток, открывая их любым вирусам и бактериям, и нарушают обмен веществ, вызывая отравления и болезни.
Каким образом плесень может попасть в организм? Самым прямым – через рот, нос и кожные покровы. То есть при употреблении в пищу заплесневелых продуктов, вдыхании зараженного воздуха и непосредственном контакте с плесенью. К сожалению, даже в сравнительно чистой комнате в одном кубометре воздуха может находиться до 500 спор, которые оседают на поверхность предметов и прорастают при благоприятных условиях (плохая вентиляция, высокая влажность и тепло свыше +20 градусов). Есть также виды плесени, способные жить при невысокой температуре и влажности.
Где появляется плесень? Излюбленное место – например, ванная комната. Плесень может поселиться и на деревянных и кожаных предметах, на бумаге, на стенах и потолках, на тканях, в горшках комнатных растений, на продуктах питания. Размножается плесень с невероятной скоростью, захватывая ближайшие поверхности – на небольшом участке количество грибков, активно образующих новые споры, быстро доходит до нескольких миллиардов.
Как же обезопасить себя от плесени?
Ни в коем случае нельзя употреблять в пищу продукты питания, пораженные плесенью! Это только на первый взгляд кажется, что если срезать с буханки хлеба пятнышко плесени, хлеб можно смело есть. Это не так, буханка поражена полностью – грибница глубоко проросла внутрь, а споры уже усеяли поверхность. Если даже на хлебе не видно пятен плесени, но он ею пахнет – такой хлеб есть нельзя.
Нередко и твердый сыр в холодильнике покрывается пятнышками плесени – даже в таких условиях ее споры умудряются прорастать! И как ни странно, есть исследователи, которые считают, что такой сыр можно использовать в пищу после термической обработки (для пиццы и т.п.) или срезав толстым слоем (до 1 см) пораженную поверхность. Не будем спорить с учеными, лучше будем покупать сыр небольшими порциями и съедать свежим, не дожидаясь появления плесени.
Для справки. Есть деликатесные сорта сыра с плесенью, на которых ее выращивают искусственно и в стерильных условиях, используя более-менее безвредные для организма виды плесени. Такой сыр и сыр, заплесневевший в холодильнике – «две большие разницы». Кстати, людям, страдающим аллергией или астмой, такой деликатес есть крайне нежелательно.
Никогда не жалейте варенье, имеющее на поверхности хотя бы пятнышко плесени, и не думайте, что его можно перекипятить и таким способом обеззаразить. Это заблуждение. Выбрасывайте, здоровье дороже! Микроскопические грибки и их споры внутри пораженного продукта находятся даже в большем количестве, чем на поверхности. Термическая обработка уничтожает лишь часть грибков, а токсические продукты их жизнедеятельности (ученые выделили около 100 их видов!) – устойчивые низкомолекулярные соединения, которые от кипячения не разрушаются.
Это же правило относится к ягодам, фруктам, овощам. Если в емкости с ягодами есть заплесневевшие – лучше выбросить все, споры уже отсеялись, можно легко отравиться. Если на фруктах или овощах есть пятна плесени, загнившие участки – то же самое, отправляйте их без сожаления в мусорное ведро. Никаких компромиссов!
Безусловно, небольшой кусочек от пораженного плесенью продукта не приведет к смертельному исходу, но вред принесет, нарушив нормальную работу желудочно-кишечного тракта и печени и заставив организм лишний раз бороться с токсинами.
Конечно, не все так безнадежно в этом противостоянии, природа предусмотрительно наделила человека естественной защитой от плесневых грибков. Ею является населяющая наш организм полезная микрофлора – на коже, на слизистых, внутри организма. Но если ее баланс нарушен, а иммунитет снижен, то последствия рано или поздно дадут о себе знать. Поэтому, с одной стороны, многое зависит от личного иммунитета, а с другой – от количества и вида плесневых грибков в помещении.
Как же предотвратить появление плесени и как с ней бороться, если она все-таки появилась? Мы знаем, какие условия благоприятствуют возникновению этого ненужного соседства, значит, наша задача – сделать их неблагоприятными.
В ванной нужно наладить хорошую вентиляцию, почаще проветривать эту комнату, особенно после принятия ванны или душа, и обрабатывать плитку в труднодоступных местах специальными средствами бытовой химии. Уделите особое внимание вентиляции в санузле, если там находятся трубы централизованного горячего и холодного водоснабжения, нередко на них выступает конденсат, способствуя появлению сырости.
В кухне при приготовлении пищи закрывайте дверь, включайте вытяжку или, если ее нет, открывайте форточку. Тогда в другие комнаты не будут попадать испарения, способствуя повышению влажности. Жилые комнаты регулярно проветривайте в сухую погоду.
Мебель в комнатах не следует ставить впритык к стенам, особенно наружным. Когда между стеной и мебелью минимальный зазор, велика вероятность образования конденсата из-за плохой вентиляции.
Выстиранную одежду тщательно просушивайте, перед тем как класть в шкаф, иначе плесень с комфортом разместится на теплых полках. Вымытую посуду ставьте в сушилку или вытирайте насухо, тогда в кухонных шкафчиках не появится сырость.
Грибки плесени боятся воздействия температуры свыше +40 градусов. Это нужно использовать в борьбе с нею. Места, где обнаружена плесень, желательно зачистить с помощью влажной губки, а потом обработать горячим (40 – 60 градусов) 4%-м содовым раствором. Буфет, кухонные шкафчики, хлебницу, холодильник вообще полезно для профилактики периодически обрабатывать горячим раствором соды, а затем протирать столовым уксусом и проветривать.
Если же при соблюдении всех профилактических мер плесень появляется на деревянных предметах мебели, это означает, что для ее изготовления использовалась древесина, не обработанная антисептиком или изначально пораженная плесенью. С такой мебелью придется расстаться, плесень с нее вывести невозможно, а вот получить источник грибковых спор – запросто.
Если пятна плесени появились на потолке, стенах, то нужно тщательно удалить колонии грибков вместе со старой штукатуркой и нанести специальное средство для борьбы с плесенью, соблюдая меры предосторожности, согласно прилагаемой инструкции. После чего сделать необходимый ремонт с применением противогрибковых препаратов (отдельно или в составе стройматериалов).
Плесень – коварная гостья в доме, но ее появление можно предотвратить. Если хорошенько высушить помещения и не допускать появления в них сырости, то и плесени там не будет. В чистой, сухой, хорошо отапливаемой и проветриваемой квартире она жить не сможет.